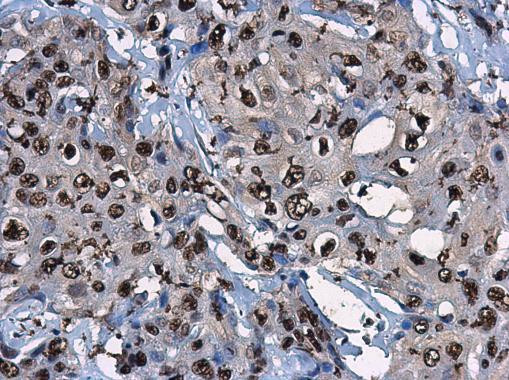
p14ARF Antibody in Immunohistochemistry (Paraffin) (IHC (P))

Search
Invitrogen
p14ARF Polyclonal Antibody
{{$productOrderCtrl.translations['antibody.pdp.commerceCard.promotion.promotions']}}
{{$productOrderCtrl.translations['antibody.pdp.commerceCard.promotion.viewpromo']}}
{{$productOrderCtrl.translations['antibody.pdp.commerceCard.promotion.promocode']}}: {{promo.promoCode}} {{promo.promoTitle}} {{promo.promoDescription}}. {{$productOrderCtrl.translations['antibody.pdp.commerceCard.promotion.learnmore']}}
图: 1 / 5
p14ARF Antibody (PA5-85606) in IHC (P)





Please note: We are reviewing Western blot images included in the antibody testing data in our catalog, including those provided by third parties. Unless expressly labeled or annotated as “raw-unedited”, Western blot images included in the antibody testing data in our catalog may have been edited, optimized or otherwise adjusted for presentation.
产品信息
PA5-85606
种属反应
宿主/亚型
分类
类型
抗原
偶联物
形式
浓度
规格
纯化类型
保存液
内含物
保存条件
运输条件
RRID
产品详细信息
Keep as concentrated solution.
Positive Control: HeLa.
Store product as a concentrated solution. Centrifuge briefly prior to opening the vial.
靶标信息
The INK4a locus on chromosome 9p21 is frequently affected in human tumors. It encodes two structurally distinct tumor suppressor proteins, p16INK4a and the alternative reading frame protein, ARF (p14ARF in human and P19ARF in mouse). These two proteins interact with the upstream proteins: retinoblastoma protein and p53 tumor suppressors, respectively. Each of these proteins has a role in the senescence of primary cells, activates pathways for cell cycle control and tumor suppression. The p14ARF (or P19ARF in mouse) proteins can induce both G1 and G2 phase arrest in a manner that depends on functional p53. The mouse and human ARF proteins have different functions in tumor suppression; this distinction may contribute to the different levels of tumor proneness of these species.
仅用于科研。不用于诊断过程。未经明确授权不得转售。
篇参考文献 (0)
生物信息学
蛋白别名: Alternative reading frame; ARF; CDK4I; Cyclin-dependent kinase 4 inhibitor A; Cyclin-dependent kinase inhibitor 2A; inhibits CDK4; MTS-1; Multiple tumor suppressor 1; p14 p16; p14ARF; p16-INK4; p16-INK4a; P19 TP16; Tumor suppressor ARF
基因别名: CDKN2; CDKN2A; MLM; MTS1
Entrez Gene ID: (Human) 1029